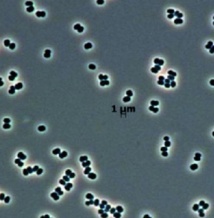

Autres articles
-
La météo extrême de l'été 2025 a coûté 43 milliards d'euros à l'Europe
-
Canada: La fumée des incendies de 2023 a fait plus de 80.000 morts dans le monde
-
Contre l'obésité infantile, informer les parents ne suffit pas
-
Le réchauffement climatique associé à une consommation accrue de boissons sucrées et de glaces aux Etats-Unis
-
Des chercheurs reconstituent l'arbre généalogique de météorites
Pas besoin d’aller dans l’espace pour trouver de nouvelles formes de vie ! La NASA a récemment découvert au sein de deux salles blanches, une nouvelle bactérie super résistante. Les micro-organismes ont été identifiés au sein du Centre spatial Kennedy, en Floride et dans le Centre spatial guyanais, situé près de Kourou en Guyane française.
Les salles blanches sont des pièces stérilisées et hautement contrôlées dans l’objectif de minimiser l’introduction d’organismes extérieurs. Dans le cas de l’agence spatiale américaine, ces lieux servent pour l’assemblage de pièces des véhicules spatiaux. Autant dire que l’environnement interne est très inhospitalier. Pourtant, c’est bel et bien là que le nouvel organisme a été découvert.
La super bactérie, baptisée Tersicoccus phoenicis, mesure environ un micromètre, soit un millionième de mètre. Elle a la forme d’une baie et est capable de survivre presque sans ressource nutritive. Selon les chercheurs, il s’agit non seulement de la découverte d’une nouvelle espèce, mais également d’un nouveau genre d’organisme, selon l’étude parue dans la revue International Journal of Systematic and Evolutionary Microbiology.
La mise en évidence de micro-organismes dans des salles blanches ne date pas d’hier, d’autres ont été relevés dans le passé. Toutefois, la découverte simultanée de la même bactérie dans deux salles différentes, situées à 4.000 kilomètres de distance est une grande première. Les unicellulaires qui se développent dans les salles stérilisées sont super résistants et habitués à vivre dans des environnements extrêmes.
Ils survivent ainsi à de forts stress liés aux agents chimiques ou aux traitements à rayons ultraviolets et sont capables de survivre au manque de ressources nutritives. Selon Parag Vaishampayan, microbiologiste au sein du Jet Propulsion Laboratory, Tersicoccus phoenicis est complètement différente des autres bactéries connues à ce jour.
Il ajoute dans un communiqué : “Elle pourrait avoir été trouvée dans un environnement naturel à faible niveau nutritif comme dans une grotte ou dans le désert”. Les chercheurs s’attèlent désormais à une inspection minutieuse des salles blanches afin d’éviter que quelques organismes indésirables s’invitent aux voyages dans l’espace.
Les salles blanches sont des pièces stérilisées et hautement contrôlées dans l’objectif de minimiser l’introduction d’organismes extérieurs. Dans le cas de l’agence spatiale américaine, ces lieux servent pour l’assemblage de pièces des véhicules spatiaux. Autant dire que l’environnement interne est très inhospitalier. Pourtant, c’est bel et bien là que le nouvel organisme a été découvert.
La super bactérie, baptisée Tersicoccus phoenicis, mesure environ un micromètre, soit un millionième de mètre. Elle a la forme d’une baie et est capable de survivre presque sans ressource nutritive. Selon les chercheurs, il s’agit non seulement de la découverte d’une nouvelle espèce, mais également d’un nouveau genre d’organisme, selon l’étude parue dans la revue International Journal of Systematic and Evolutionary Microbiology.
La mise en évidence de micro-organismes dans des salles blanches ne date pas d’hier, d’autres ont été relevés dans le passé. Toutefois, la découverte simultanée de la même bactérie dans deux salles différentes, situées à 4.000 kilomètres de distance est une grande première. Les unicellulaires qui se développent dans les salles stérilisées sont super résistants et habitués à vivre dans des environnements extrêmes.
Ils survivent ainsi à de forts stress liés aux agents chimiques ou aux traitements à rayons ultraviolets et sont capables de survivre au manque de ressources nutritives. Selon Parag Vaishampayan, microbiologiste au sein du Jet Propulsion Laboratory, Tersicoccus phoenicis est complètement différente des autres bactéries connues à ce jour.
Il ajoute dans un communiqué : “Elle pourrait avoir été trouvée dans un environnement naturel à faible niveau nutritif comme dans une grotte ou dans le désert”. Les chercheurs s’attèlent désormais à une inspection minutieuse des salles blanches afin d’éviter que quelques organismes indésirables s’invitent aux voyages dans l’espace.